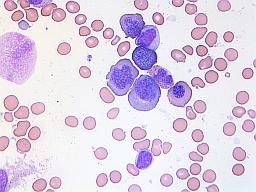
Image

Diagnose: Wie wird eine megaloblastäre Anämie festgestellt?
Autor: Dr. med. habil. Gesche Tallen, Zuletzt geändert: 22.04.2021 https://kinderblutkrankheiten.de/doi/e224578
Die Diagnose einer megaloblastären Anämie und deren Ursache müssen gesichert sein, damit sie richtig behandelt werden kann. Besteht bei einem Kind oder Jugendlichen beispielsweise aufgrund der Familiengeschichte, Ernährungsgewohnheiten, dem Bestehen gewisser anderer Krankheiten oder der Einnahme bestimmter Medikamente (siehe „Ursachen“) oder auch wegen typischer Krankheitszeichen (siehe „Krankheitszeichen“) der Verdacht auf einen Vitamin B9- beziehungsweise -B12-Mangel, wird der Arzt verschiedene Untersuchungen veranlassen, um herauszufinden, ob es sich um eine megaloblastäre Anämie handelt.
Dazu gehören insbesondere Untersuchungen wie:
- Bestimmung von Größe/Volumen (so genanntes mittleres korpuskuläres Volumen, MCV) sowie Anzahl der verschiedenen Blutzellen, insbesondere der roten Blutzellen (Erythrozyten), deren Gehalt an rotem Blutfarbstoff (Hämoglobin) und deren Vorstufen (Retikulozyten) im Blut und manchmal, in unklaren Situationen, auch eine Knochenmarkpunktion
- Differentialblutbild
- Bestimmung der Folat-Konzentration der Erythrozyten (bei Folat- und bei Kobalaminmangel erniedrigt)
- Bestimmung von Folat im Serum (bei Folatmangel erniedrigt)
- Bestimmung von Methylmalonsäure im Serum oder im Urin (bei Kobalaminmangel erhöht)
- Bestimmung von Homozystein im Serum (bei Folat- und Kobalaminmangel erhöht)
- Bestimmung der Kobalaminaufnahme im Dünndarm (so genannter Schilling-Test: orale Gabe von radioaktiv markiertem Kobalamin und später Messung der im Urin ausgeschiedenen Menge) - nicht normal bei gestörter Kobalamin-Aufnahme (siehe „Ursachen“)
- Bestimmung von Antikörpern gegen Intrinsic Faktor (siehe „Ursachen“) und/oder Magenschleimhautzellen (nachweisbar bei Kobalaminmangel aufgrund perniziöser Anämie) (siehe „Ursachen“)
Die zuverlässige Diagnosestellung einer megaloblastären Anämie ist komplex und sollte daher durch Spezialisten für Kinderblutkrankheiten erfolgen. Eine Liste mit Kliniken mit kinderhämatologischen Abteilungen und Ambulanzen finden Sie hier.